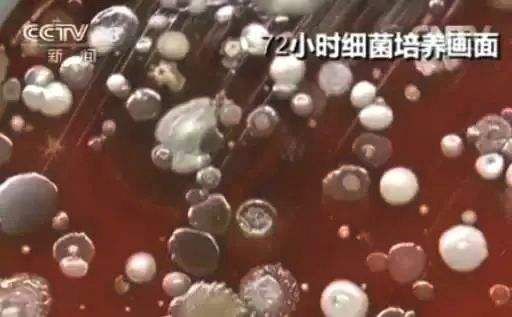
免洗手凝胶小孩子可以用吗,免水洗手消毒凝胶儿童

目前新型冠状病毒 传染来源尚未找到,也没有特效药,现阶段预防大于治疗,防范于未然,才是关键。
科学防护要点: 戴口罩,勤洗手,少去人群聚集处。

戴口罩能护住口鼻,手却时刻在外面。看起来干干净净的双手,其实是细菌的大本营。
央视曾经报道过:人经过一天的活动,双手细菌高达1000万! 指甲缝里的病毒超过30万只!
老话四个字说的铿锵有力:病从口入!
我们用手吃饭、吃零食。吃进去的可都是数以百万的细菌啊!
有宝宝的家庭就更头疼了,前一秒宝宝还在摸地板,后一秒就已经开始吃手了!一不小心就造成细菌感染,导致腹泻、感冒、胃肠道疾病!

所以说,正确洗手很重要!
但...你用什么洗手?很多人会用公共场所提供的洗手液来洗。但央视采样实验发现:公共场所的洗手液,细菌超标600倍!

经过我们一番寻找,才给大家找到了真正好用、抑菌的免水洗洗手液!LARGE泡腾免水洗洗手液▼

【10片装 送按压瓶】泡腾洗手液套装
免洗有效防止病菌 70% 富含芦荟提取物 点击小程序购买1片泡腾片+250ml清水=1瓶洗手液! 5秒自制一瓶洗手液,洁净又卫生!
演示一下用法——
喷瓶装上纯净水,把泡腾片往里一丢,开始咕嘟嘟冒泡。

15分钟后,这瓶洗手液就“做好了”。
按下泵头,真的有非常细腻绵密的泡泡出来。

我手上刚好有刚 吃饼干留下的巧克力酱,用它洗洗,哇!真的好干净。

泡沫特清爽,用水一冲就走,不会有假滑粘腻感。香味淡淡的,好闻又好用!

了解完这款洗手液后,当即就打算推荐给你们。
首先它是免水洗的。在手上揉搓几秒泡沫就会消失,比水冲的还净。

像宝妈们带孩 子出门弄脏了手,大街上又找不到水龙头,包里装瓶它,搓搓就干净了,特别方便。

办公室吃完炸鸡、薯片等小零食,手上会黏黏的很难受,用纸巾擦不掉。 它就是我们懒癌的救星啊!一洗干干净净,不用再跑到洗 手间啦。

去逛商场或电影院,不想在厕所排长队,随身带一瓶,走到哪都能洗。

家里饭桌上也可以放一瓶,宝宝吃饭不愿意洗手。用它洗洗,无需水冲,消毒抑菌。

经常要出差的朋友也用得上,高铁、飞机、火车都能带,没必要再挤公厕了。 总之,厨房、宾馆、办公室、逛街出行...到哪都离不开它,方便好用。

除了免水洗,它还有个优点就是保湿不伤手。
现在是冬季,天气干得不行。每次洗完手皮肤都很紧绷。
这瓶洗手液的泡腾片是含有76%的芦荟提取物的。保湿滋养皮肤,怪不得洗完后双手都水润漂亮了~

最后这个心动的理由,大家就更没法拒绝了——它实在太太太划算了!
一盒洗手液含 10片独立包装泡腾片,送慕斯瓶一只 !

毕竟家里、公司都得用上。多囤多划算!担心用不完的小伙伴,也可以和同事朋友拼单!
LARGE泡腾洗手液套装 免洗有效防止病菌 70% 富含芦荟提取物 点击小程序购买
01 清洁成分 温和不伤手
前面说到市面上的洗手液会发粘、假滑,而这款的使用感就超好。
为啥?这得归功于它厉害的成分。
一般的洗手液成分是阴离子活性剂,也就是皂基。再加上一些廉价香精,洗到手上是又滑又腻。

而LARGE的主要成分是月桂酰谷氨酸钠。也就是氨基酸表面活性剂。 提到氨基酸,朋友们肯定就不陌生了。最近非常流行氨基酸洁面,温和不刺激,无致敏性。不管是孕妇、敏感肌还是婴幼儿,都可以放心使用。

LARGE使用的氨基酸表活,更是频繁被用于高端护肤品中。
像贵的要命的SK-II洁面霜,主要成分就是它。
看看LARGE的其他几种成分,也都是非常温和的。
所以它不仅可以用来洗手,也能 用作洁面。
放一瓶在家里给男朋友,不担心大猪蹄子会偷用你的洗面奶了~

02 芦荟+甘油 洗出白嫩小手
天气干燥,若是洗手液没选好,后面补涂再多护手霜也是白瞎。
像公司卫生间和商场提供的洗手液,都是非常廉价的。洗完之后皮肤皱巴巴的,显得又老又粗糙。

要知道,双手堪称人的“第二张脸”。手的保养没做好,戴再贵的手表、戒指,看起来也像地摊货。 这瓶洗手液就特别符合我们女孩子的需求。它含有76%的芦荟提取物和甘油。 芦荟大家都知道,具有很强的保湿和抑菌消 炎性。

有了它之后,洗手再也不“伤手”,而是在护肤抑菌哦。
办公桌上放一瓶,随时可以洗一洗。保持我们双手的细嫩光滑。

还可以有效防止细菌滋生,家里有宝宝的,别再花钱买超市货了,用这个更卫生。

除了洗手,也能拿下擦桌子、擦键盘、擦手机..让我们周围的环境都香香甜甜,健康无细菌。

LARGE泡腾洗手液套装 免洗有效防止病菌 70% 富含芦荟提取物 点击小程序购买
03 国际认证大品牌 品质信得过
在产品安全方面,这款做得也让人特别满意。
因为现在市面上在售的泡腾洗手液,大部分都是含酒精的。 新闻就报道过洗手液遇到明火,立刻被点燃的情况。这种洗手液安全性低,万万用不得。

小编推荐的这款,它不含酒精、香精、无有害化学成分。

质检报告奉上,大家也会多一份安心。

对于LARGE的品牌,我也经过了一番考量。
它与方太、海尔、西门子、美的等大企业都有合作,产品还通过了国际认证联盟IQ NET和CQC质量安全体系认证。
2017年更是与美国亚太区多家国内外知名企业达成合作关系,是真正让人信赖的品牌。

原价99/件 现粉丝优惠 价仅需 1件59元! 2件108元!
